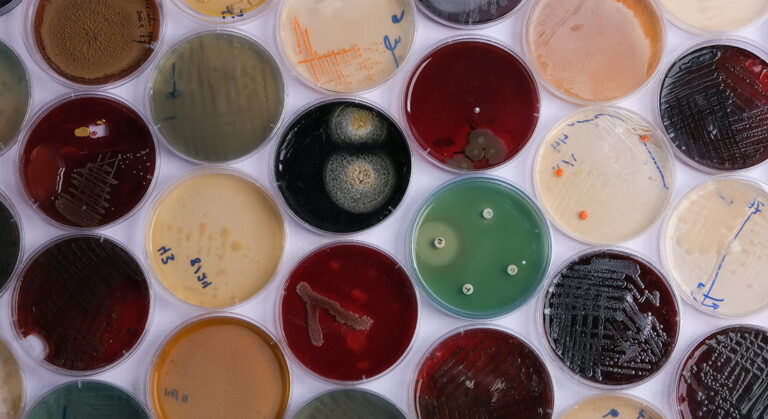
collection of culture plates contain growth of microorganisms on different agar media

AgxPure®: Tecnología avanzada de purificación de agua por electrocoagulación.
El núcleo de nuestra oferta es AgxPure®, un innovador proceso continuo para el tratamiento de agua basado en los principios de la electrocoagulación. La fuerza impulsora de nuestro proceso es la electricidad, que activa una serie de mecanismos para purificar el agua de forma rápida y eficiente.
En cuestión de minutos, AgxPure® separa el agua contaminada en dos fracciones:
- Agua Limpia: Purificada y lista para su reutilización o descarga segura.
- Fase Sólida Seca: Contaminantes concentrados en flóculos secos y manejables.
Ventajas Clave del Proceso AgxPure®
- Sin Generación de Lodos: A diferencia de los tratamientos tradicionales, nuestro sistema no produce lodos líquidos ni flujos de concentrado que requieran manipulación o tratamiento adicional.
- Proceso Rápido y Continuo: La purificación se completa en minutos, permitiendo un alto rendimiento y eficiencia operativa.
- Amplio Espectro de Eliminación: Es una solución integral que remueve una vasta gama de contaminantes en un solo proceso.
- Eliminación Eficaz de Contaminantes.
La tecnología AgxPure® está diseñada para eliminar la mayoría de los contaminantes tóxicos y problemáticos, incluyendo:
- Sólidos y Metales: Sólidos en suspensión y iones de metales de transición.
- Nutrientes y Orgánicos: Fósforo y compuestos orgánicos.
- Contaminantes Emergentes: PFAS, microplásticos y residuos farmacéuticos.
- Otros: Microorganismos, aceites y grasas emulsionadas.
Aplicaciones Ideales
El sistema AgxPure® es especialmente adecuado para la purificación de:
- Aguas residuales y de procesos industriales.
- Lixiviados de vertederos y zonas de almacenamiento.
- Aguas pluviales contaminadas por actividades industriales y de otro tipo.
Recursos y Consumibles del Proceso
Para su operación, el sistema AgxPure® requiere:
- Electrodos de Sacrificio: Ubicados dentro del reactor, su reemplazo periódico es parte del mantenimiento programado.
- Electricidad: Preferiblemente de fuentes renovables (verde).
- Polímero Floculante: Para optimizar la aglomeración de los sólidos.
- Ajuste de pH (Según Necesidad): Se puede requerir ácido o base dependiendo de las características del agua de entrada.